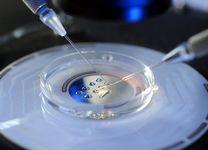

中新网1月12日电 香港《明报》日前刊文称,冷冻卵子技术渐成美国职业女性延迟生育时间、继续为事业拼搏的普遍方式,带来庞大商机。投资者分析指出,越来越多年轻未婚女性为发展事业而晚婚晚育,考虑选用冷冻卵子保障未来生育机会,相信行业大有可为,更有科技公司资助女员工冷冻卵子,吸引留职效力。不过专家指出,此技术不保证女性产下后代,警告女性付出大量金钱可能只换来假希望。

文章摘编如下:
美国个案大增 “像月经一样平常”
纽约曼哈顿市中心一幢高级商厦中,10多名年轻女子聚首一堂,了解冻卵服务计划。35岁的地产经纪弗洛兰斯·吴(Florence Ng)去年刚接受冻卵服务,她自言工时长且压力大,“根本没时间约会”,但希望有一天能生儿育女。在她眼中,冻卵等同为生育能力“买保险”,以争取时间专注在职场发热发光,“今天的女性更需要谈论冷冻卵子,它就像月经一样重要”。
有此想法的女性在美国不在少数。美国辅助生殖技术协会(SART)统计,美国采用冻卵技术保存卵子的女性由2009年的475人增至2013年的近4000人,有业界人士估计,现今选择冻卵的女性达数以万计,主要为30出头又未婚的职业女性。
企业资助冻卵 吸引女员工
一般女性在20多岁时的卵子最健康,到30多岁时卵子数量和质量下降,至40多岁时需借卵产子的可能亦大增。冻卵技术被视为延长女性生育期限的可行方案,这种程序每次约需1.5万美元(约合人民币97200元),一般需做两次以收集足够数量卵子,保存费约每年500美元,对初投职场的女性来说价格不算便宜。
2014年,美国两家科技业公司宣布资助女员工冷冻卵子,增加她们延后怀孕、专注事业的机会,成业界先例,随后微软等巨企亦陆续推出类似福利吸引女员工,投资者亦对冻卵商机日感关注。
投资银行Capstone Partners去年初表示,女性为追求事业成就及确立财政保障,延后结婚生子已成趋势,辅助生育服务需求随之急增。市场研究机构Reportlinker去年12月报告指出,2017年美国辅助生育产业规模估计已达36亿美元,不少投资者已展开相关并购,诊所亦大搞简介会招客。由私募基金North Peak Capital拥有的冷冻卵子专门诊所Extend Fertility预期,冷冻卵子业务“将以几何级数增长”,有信心公司每年可吸纳5万女性光顾。
成功率不足24% 专家吁谨慎
不过医学专家对于藉由冷冻卵子延后生育限期的成效不感乐观。SART数据显示,2012年冷冻的353颗卵子中,只有83颗最终孕育成婴儿,2013年冷冻的414颗卵子只产下99个婴儿,即成功率不足24%。
SART主席杜迪(Kevin Doody)指出,要成功受孕,年龄是重要因素,38至40岁女性成功产子的机率已低于四分之一,接受人工受孕的成功率亦较年轻女性低。
美国生殖医学会亦表明,虽然冷冻卵子技术完成实验阶段,但没足够数据支持女性适合以此技术延迟生育。学会指出,38岁或以下女性,以冷冻卵子孕育婴儿的成功率仅2%到12%,警告相关推广“可能给予女性假希望”。